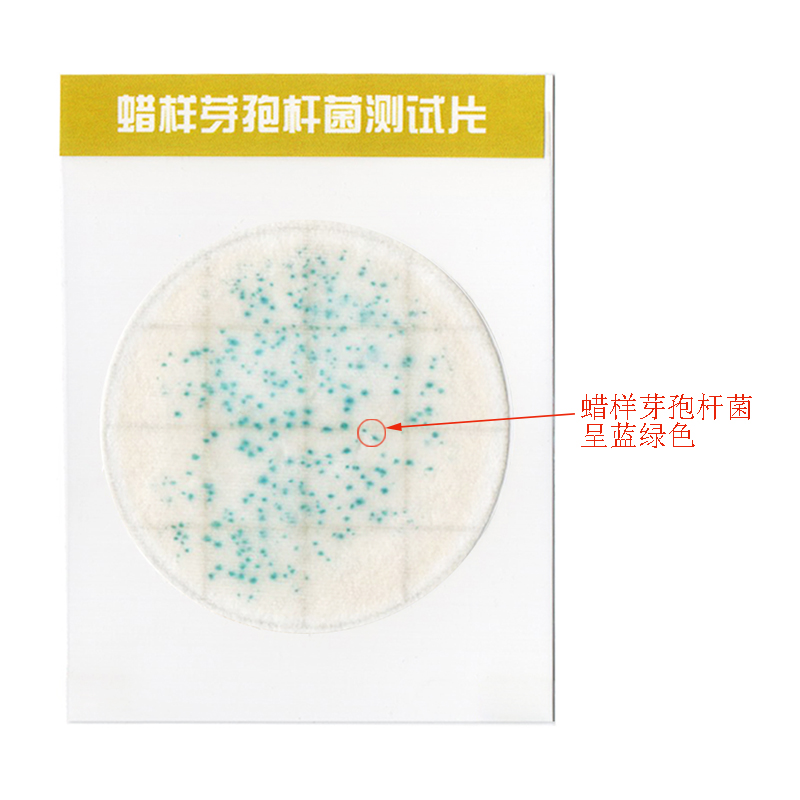
蠟樣陽性.jpg

蠟樣芽孢桿菌測試片(Ⅱ代)
參照標(biāo)準(zhǔn):食品衛(wèi)生微生物學(xué)檢驗 蠟樣芽孢桿菌檢驗(GB/T 4789.14)
產(chǎn)品參數(shù):
詳細(xì)介紹:
1 原理及適用范圍
蠟樣芽孢桿菌(Bacillus cereus)在自然界分布廣泛,在各種食品中的檢出率也較高,往往是食品在食用前保存溫度不當(dāng),放置時間過長,使污染在食品中的蠟樣芽孢桿菌或殘存的芽孢得以生長繁殖,或是由于含有蠟樣芽孢桿菌產(chǎn)生的熱穩(wěn)定毒素,而導(dǎo)致食物中毒的發(fā)生。中毒的發(fā)病率較高,一般為60%~100%。
蠟樣芽孢桿菌測試片是一種商品化的一次性培養(yǎng)基產(chǎn)品,由選擇性培養(yǎng)基、高分子吸水凝膠和專一性酶指示劑等構(gòu)成,一步培養(yǎng)顯色就可確認(rèn)是否有病原菌的存在,大大地簡化了檢測程序,對于提高細(xì)菌性食物中毒突發(fā)事件的反應(yīng)能力具有重要的作用,同時也可在食品生產(chǎn)企業(yè)使用。本產(chǎn)品適用于乳制品、肉類、淀粉類食品、各種甜點(diǎn)等的快速檢測。
參照標(biāo)準(zhǔn):食品衛(wèi)生微生物學(xué)檢驗 蠟樣芽孢桿菌檢驗(GB/T 4789.14)。
2 操作方法
2.1 樣品處理:取樣品 25 mL(g)放入含有225 mL滅菌磷酸緩沖液稀釋液(或生理鹽水)的取樣罐或均質(zhì)杯內(nèi),制成1:10的樣品勻液。
2.2 接種:將測試片置于平坦實驗臺面,翻開測試片蓋膜,用無菌吸管吸取1mL樣品勻液均勻地滴加到紙片上,等待紙片完全吸收液體,慢慢放下蓋膜,每個稀釋度接種兩片。同時做一片空白陰性對照。
2.3 培養(yǎng):將測試片疊在一起置于恒溫培養(yǎng)箱內(nèi),堆疊片數(shù)不超過12片。培養(yǎng)溫度為36℃±1℃,培養(yǎng)15~24h。
3 結(jié)果判讀
對測試片進(jìn)行觀察,呈藍(lán)綠色的菌落為蠟樣芽孢桿菌。對于出現(xiàn)陽性菌落的樣品,最好用其他方法作進(jìn)一步的鑒定。
4 報告方式
報告每25g(或25ml)樣品中檢出或未檢出蠟樣芽孢桿菌。
5 附加說明
5.1 本產(chǎn)品具有很好的特異性,接種蠟樣芽孢桿菌純菌株產(chǎn)生典型的藍(lán)綠色點(diǎn),而大部分非目標(biāo)菌如大腸桿菌、大腸桿菌O157、沙門氏菌、金黃色葡萄球菌、副溶血弧菌和阪崎腸桿菌等均被抑制。
5.2 注意使用過的測試片上帶有活菌,需及時按照生物安全廢棄物處理原則進(jìn)行處理 。
6 保存條件
本產(chǎn)品需存放在2℃~8℃冰箱中,保質(zhì)期為一年。